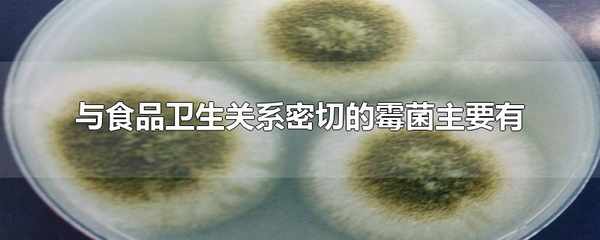

與食品衛生關系密切的黴菌主要有
admin
2022-06-06 23:09:05
與食品衛生關系密切的黴菌主要有曲黴菌屬、青黴菌屬和鐮刀菌屬。黴菌是真菌的一種,其特點是菌絲體較發達,無較大的子實體。同其他真菌一樣也有細胞壁,以寄生或腐生方式生存。黴菌是形成分枝菌絲的真菌的統稱。
與食品衛生關系密切的黴菌主要有
黴菌是絲狀真菌的俗稱,意即“發黴的真菌”,它們往往能形成分枝繁茂的菌絲體,但又不像蘑菇那樣產生大型的子實體。
黴菌有的會使食品轉變為有毒物質,有的可能會在食品中產生毒素,即黴菌毒素,對人體健康造成的危害極大。
影響黴菌生長繁殖及產毒的因素是很多的,與食品關系密切的有水份、溫度、基質和通風等條件。因此,控制這些條件可以對食品中黴菌的分佈及產毒造成很大的影響。
上一篇:問卷調查的作用及意義
下一篇:聖誕節賀卡裡面寫什麼
相关内容
热门资讯
元旦家宴推荐!10道简单又下饭...
元旦将至,许多家庭都会选择团聚庆祝,享受美食。然而,准备丰盛的家宴往往让人感到压力,尤其是对于那些忙...
元旦家宴,6道超好吃凉拌菜,清...
元旦家宴,凉拌菜先上桌,6道超好吃凉拌菜,清爽开胃,喝酒人最爱! 元旦家宴,一家人团聚一堂,满桌的大...
今日最新早上好表情图片,一声早...
1.清晨的阳光,洒满了一天的喜悦;清新的空气,送来了健康的气息。愿你的心情像那初升的太阳一样温暖,愿...
葡萄酒与美食的完美配对,一篇搞...
你是否曾在餐桌上纠结过:该选哪款葡萄酒来搭配今晚的晚餐?是选择一瓶温润的红酒,还是开一瓶清爽的白葡萄...
十分钟搞定营养早餐,学会这招让...
生活的基石是一日三餐,其中闪耀的愉悦是美食。它不只是用来果腹的东西,更是连接情感、记录日常的独特语言...
